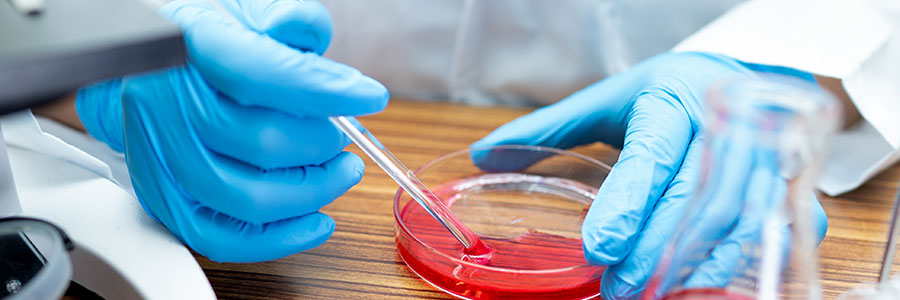
chemotherapy-treatment-siliguri

Chemotherapy is a common but powerful drug treatment that is used to kill cancer cells in your body which also helps to prevent tumor growth. Depending on the condition, this treatment is used alone or in combination with other treatments such as radiation therapy or cancer surgery.
If you are a cancer patient or have noticed any symptoms of cancer in your body, feel free to consult Dr. Arkoprovo Halder, a renowned name in cancer treatments to get comprehensive chemotherapy treatment in Siliguri for betterment. Like other cancer treatments, chemotherapy treatment also carries a risk of side effects.
Mild side effects are common and 100% treatable while others have serious complications. Not only cancer but chemotherapy is also used in bone marrow diseases, and immune system disorders, and doctors named this treatment neo-adjuvant therapy.
Depending on the type, stage, previous cancer treatments, your goals and preferences, and your overall health condition Dr. Arkoprovo Halder will decide your treatment options such as chemotherapy. After the treatment, depending on the characteristics of your cancer, and how your body responds to the treatment, your doctor will decide how often you will receive the best chemotherapy treatment in Siliguri.
Usually, chemotherapy drugs can be given through infusions, pills, shots, or creams, directly to one area of the body, and directly given to the tumor. During the treatment, you must visit your oncologist and follow up on all the necessary guidelines accordingly for quick recovery.
If you have any questions or queries about chemotherapy treatment such as its costs, benefits, risks, and side effects, then feel free to talk to Dr. Arkoprovo Halder, MD - Radiotherapy, DM - Medical Oncology (Kidwai Cancer Institute, Bangalore), Medical Oncologist at - +91 8001179000 and discuss all your issues accordingly.
(Kidwai Cancer Institute, Bangalore)
Medical Oncologist
10 Years of Experience